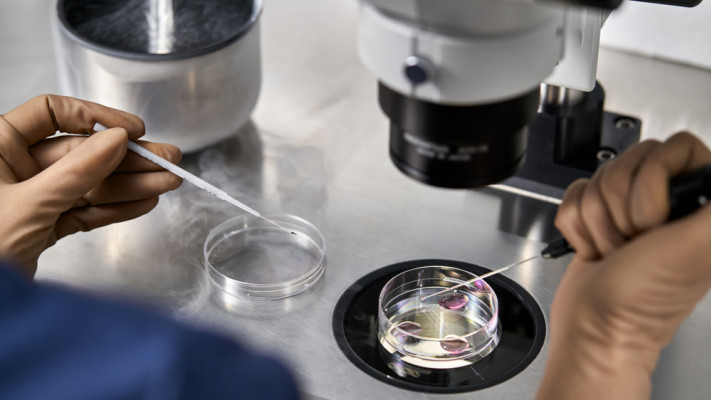
מעבדת פוריות. ההקפאה הראשונית לחמש שנים (צילום: שאטרסטוק)

התהליך שנותן סיכוי נוסף להורות: ישראל היא בין המדינות המובילות בעולם בתחום הפוריות ומהראשונות לאפשר הקפאת ביציות, הליך שנותן סיכוי להרות לנשים שעוברות את הגיל הגבולי לסיכוי להורות, באמצע העשור הרביעי. השבוע חשפה משפיענית הרשת מעיין אדם על כך שלא תוכל להרות, אך הקפיאה ביציות. איך מתבצע ההליך, כמה זה עולה, ולכמה זמן אפשר לשמור ביציות?
הקפאת ביציות היא פרוצדורה רפואית מתקדמת שמעניקה אפשרות לדחות את ההחלטה על הבאת ילדים לגיל מאוחר יותר, מבלי לאבד את סיכויי הפוריות. ההליך הרפואי מתחיל בהזרקת הורמונים שמטרתם לגרום לשחלות לייצר מספר גדול של ביציות.
לאחר כשבועיים מתבצעת שאיבה קצרה בהרדמה קלה, במסגרתה נאספות הביציות. במעבדה הן מוקפאות בשיטה מיוחדת הקרויה "הקפאה בזיקוק מהיר", המונעת היווצרות גבישי קרח שעלולים להזיק להן. מרגע זה נשמרות הביציות במכלי חנקן נוזלי בטמפרטורה של מינוס 196 מעלות, עד שיידרשו לשימוש.
בישראל ניתן לשמור ביציות עד חמש שנים, עם אפשרות הארכה בכפוף לפנייה יזומה של האישה. משרד הבריאות קובע כי נשים רשאיות להשתמש בביציות המוקפאות עד גיל 54. יחד עם זאת, יש לזכור כי שיעורי ההצלחה אינם מובטחים ותלויים במספר גורמים, בהם גיל האישה בעת שאיבת הביציות, איכות ההקפאה ומשך תקופת השמירה.
כאשר אישה מחליטה להשתמש בביציות שהוקפאו, הן מופשרות ומופרות במעבדה בזרע במסגרת טיפול הפריה חוץ גופית. העוברים שנוצרים מוחזרים לרחם בתקווה שייקלטו. תהליך ההקפאה אינו פוגע בעובר העתידי, והילדים שנולדו בשיטה זו נחשבים בריאים בדיוק כמו ילדים מהריונות טבעיים, אם כי משרד הבריאות מציין כי היקף המידע עדיין מוגבל משום שהטכנולוגיה חדשה יחסית.
הקפאת ביציות נעשית משתי סיבות מרכזיות: רפואיות ולא רפואיות. מהצד הרפואי מדובר בנשים העומדות בפני טיפולים כימותרפיים או הקרנות העלולים לפגוע בפוריות, נשים עם אנדומטריוזיס או מחלות גנטיות המעלות סיכון לאובדן מוקדם של תפקוד השחלות, וכן נשים הנדרשות לניתוחים הכרוכים בכריתת שחלות. מהצד הלא רפואי, נשים בגילאי 22 עד 41 יכולות לבחור לשמר ביציות מתוך שיקולים אישיים, זוגיים או מקצועיים.
כמות הביציות הנשאבות משתנה לפי גיל. לנשים צעירות יותר, עד גיל 36, ניתנת האפשרות לבצע עד שש שאיבות אך אין הגבלה על כמות הביציות הנאגרת. לרוב מקובל לאגור עד 35 ביציות, כשהמטרה היא להשיג כמות מספקת של ביציות על מנת להגדיל את סיכויי ההיריון העתידיים.
עלות התהליך משתנה בהתאם לסיבה. כאשר מדובר בצורך רפואי, התהליך כלול בסל הבריאות וממומן על ידי קופות החולים, כולל התרופות. מנגד, בסיבות שאינן רפואיות, העלות נעה לפי תעריפון משרד הבריאות בין 7,000 ל־9,000 שקלים למחזור שאיבה אחד. לעיתים יש צורך במספר מחזורי שאיבה כדי להגיע לכמות מספקת של ביציות, מה שמגדיל את העלות הכוללת. עלות שימור הביציות עצמן לחמש שנים עולה כאלף שקלים. ניתן להאריך את השימור בהקפאה בתשלום.
ומה לגבי הסיכונים? מדובר בפרוצדורה בטוחה יחסית, אך קיימים סיכונים נדירים כמו דימום או זיהום לאחר השאיבה. גם הטיפול ההורמונלי עלול לגרום לגירוי יתר שחלתי, מצב שלרוב חולף תוך ימים ספורים. רוב הנשים מתאוששות במהירות ויכולות לשוב לשגרת חייהן כבר ביום למחרת.
הנתונים בעולם מצביעים על עלייה מתמדת במספר הנשים שבוחרות בהליך, אך גם מזכירים שהוא לא מבטיח היריון. ההצלחה תלויה באיכות ובכמות הביציות שנשמרו, ובגיל האם בעת השימוש בהן. עם זאת, עבור רבות, עצם הידיעה שהן מחזיקות "תעודת ביטוח ביולוגית" מעניקה להן שקט נפשי ותחושת שליטה בעתידן.